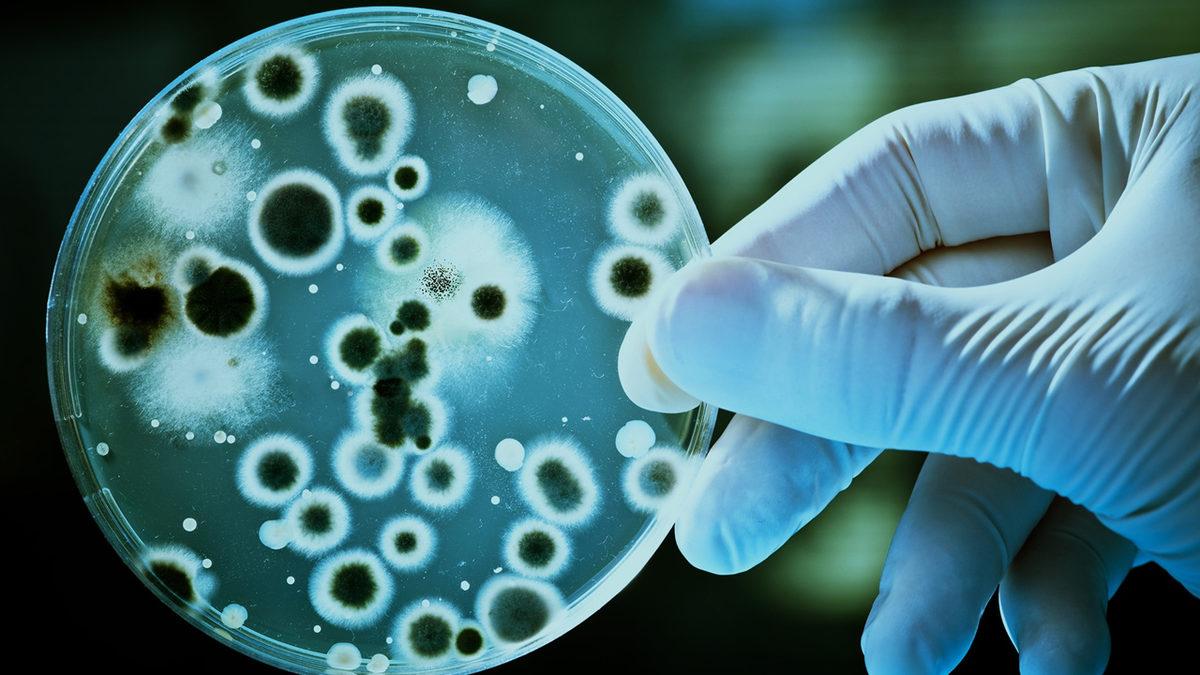
Bakteriler Dünyayı Ele Geçirmeye Karar Verse Kaç Gün İçinde Bunu Başarabilirler? (Herkesle Vedalaşamayabilirsiniz)

Son 3,5 milyar yıldır dünyada olan bakteriler, bitkiler ve hayvanlar evrimleşmeden önce koloni olarak büyüyüp geliştiler.
Vücudumuzda trilyonlarcası yaşıyor, her an nefes alıp verdiğimiz havada ve hatta içtiğimiz su da bile varlar. Her yerdeler ama ya bir gün dünyanın hakimi olsalar?
Bakteriler ne kadar hızlı çoğalır?

Dünyayı yemeden önce onları çoğaltmak gerekiyor ki bu konuda da pek bir marifetliler. Uygun koşullarda her 20 dakikada bir bölünerek 20 dakikada ikiye, 40 dakikada dörde ve bir saat sonunda sekiz bakteriye dönüşebiliyorlar.
Böyle bir hızla çoğalmaya devam ederlerse, kısa sürede milyarlarca bakterinin oluşması işten bile değil! Ancak bu çoğalma öyle sürekli devam eden bir şey değil çünkü onların büyüyebilmesi için enerjiye ve maddelere ihtiyaçları var.
Bakterilerin sınırları neler?
Teoride hızla çoğalabiliyorlar ama pratikte çevresel faktörler çoğalmalarını sınırlıyor. Besin eksikliği, atık maddelerin birikmesi ve alan yetersizliği gibi etkenler bakterilerin büyümesini durdurabiliyor.
Bunun yanı sıra bağışıklık sistemimiz de bu küçük istilacıları durdurmak için sürekli çalışıyor. Yani bakterilerin dünyayı ele geçirme planı zannedildiği kadar basit değil.
Eğer her şey mümkün olsaydı?

Eğer bakteriler besin eksikliği ve diğer sınırlayıcı faktörlerden etkilenmeden çoğalabilseydi, dünya üzerindeki tüm yaşamı kısa sürede kaplayabilirlerdi.
Bakterilerin karbon atomu tüketmesiyle sadece birkaç gün içinde dünya üzerindeki tüm organik maddeleri kaplayabilir. Neyse ki bu senaryo oldukça uzak bir bilim kurgu senaryosu yoksa 2 günde kim bakterilerin esiri olmak ister ki!
Sonuç olarak, bakteriler çok güçlü ve etkileyici organizmalar olsa da doğanın dengeleri onların kontrolsüz çoğalmasını engelliyor.



